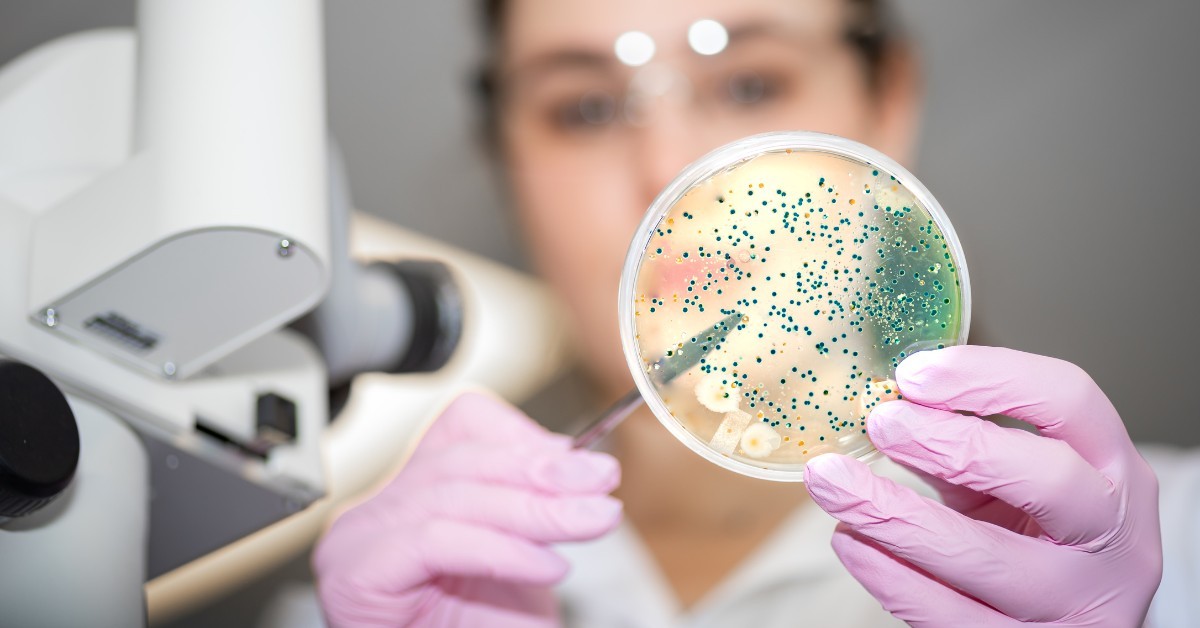

Balancing Your Skin Microbiome: The Science of Good and Bad Bacteria
The skin microbiome is a complex ecosystem of microorganisms living on your skin, playing a crucial role in maintaining its health. Understanding and balancing the good and bad bacteria can lead to clearer, healthier skin.
What is the Skin Microbiome?
The skin microbiome consists of trillions of microorganisms, including bacteria, fungi, and viruses, that live on your skin. These microorganisms protect against pathogens, help regulate immune responses, and maintain skin barrier function. The skin microbiome is influenced by various factors, including genetics, diet, environment, and skincare practices. A healthy microbiome is essential for maintaining the skin's natural barrier and preventing harmful bacteria from causing infections or inflammation.
Importance of Balancing Good and Bad Bacteria
Good bacteria promote skin health by protecting against harmful microorganisms and aiding in skin barrier repair. Conversely, bad bacteria can cause infections, inflammation, and skin conditions like acne and eczema when not kept in check. Balancing the skin microbiome involves encouraging the growth of beneficial bacteria while limiting the proliferation of harmful ones. This balance is crucial for maintaining skin health, as an imbalance can lead to various skin issues.
Factors Affecting the Skin Microbiome
Diet:
A balanced diet rich in fruits, vegetables, and probiotics supports a healthy skin microbiome. Foods high in sugar and processed ingredients can disrupt the balance, leading to skin problems.
Lifestyle:
Stress, lack of sleep, and poor hygiene can disrupt the balance of the skin microbiome. Managing stress through relaxation techniques, getting adequate sleep, and maintaining good hygiene practices can help maintain a healthy skin microbiome.
Skincare Products:
Harsh chemicals and over-cleansing can strip away beneficial bacteria. Using gentle, microbiome-friendly products helps maintain the natural balance of the skin's ecosystem.
Tips for Maintaining a Healthy Skin Microbiome
Use Gentle Cleansers:
Avoid harsh soaps and cleansers that can disrupt the skin’s natural balance. Opt for mild, hydrating cleansers that preserve the skin’s natural oils and beneficial bacteria.
Incorporate Probiotics:
Use skincare products containing probiotics to support beneficial bacteria. Probiotics help strengthen the skin barrier and reduce inflammation, promoting overall skin health.
Avoid Over-Cleansing:
Limit washing your face to twice a day to preserve natural oils and bacteria. Over-cleansing can strip the skin of its protective barrier, making it more susceptible to infections and irritation.
Stay Hydrated:
Drink plenty of water to maintain skin hydration and overall health. Hydrated skin supports a healthy microbiome and helps prevent dryness and irritation.
Manage Stress:
Practice stress-reducing techniques such as meditation, yoga, or deep breathing exercises. Reducing stress can help maintain a balanced skin microbiome and prevent stress-related skin issues.
Balanced Diet:
Eat a diet rich in fruits, vegetables, and fermented foods like yogurt and kefir. A healthy diet provides essential nutrients that support the skin's microbiome and overall health.
Maintaining a balanced skin microbiome is essential for healthy, resilient skin. By understanding the factors that affect your skin’s ecosystem and adopting gentle, supportive skincare practices, you can achieve a clearer, more radiant complexion. Healthy skin starts with maintaining a harmonious balance of good and bad bacteria, so make informed choices about your diet, lifestyle, and skincare routine. For personalized skincare advice and treatments, visit Skindays Clinic, where our experts can guide you towards achieving your best skin.



